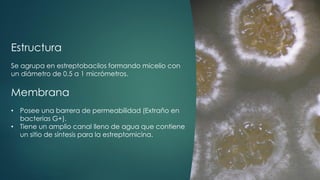
Estructura
Se agrupa en estreptobacilos formando micelio con
un diámetro de 0.5 a 1 micrómetros.
Membrana
• Posee una barrera de permeabilidad (Extraño en
bacterias G+).
• Tiene un amplio canal lleno de agua que contiene
un sitio de síntesis para la estreptomicina.

Streptomyces griseus es una bacteria gram positiva que forma estreptobacilos y produce antibióticos como la estreptomicina, utilizada en el tratamiento de tuberculosis. Su genoma es inestable y su metabolismo anaerobio permite la producción de metabolitos secundarios de interés médico, así como nanopartículas de plata para aplicaciones antimicrobianas. Esta especie se clasifica dentro del dominio de las bacterias y presenta características únicas en su estructura celular y ciclo de vida.

![Referencias
S.a. (1992). Modelo OMS de información sobre prescripción de medicamentos: Medicamentos
utilizados en las enfermedades micobacterianas [Archivo Electrónico]. Recuperado de :
http://apps.who.int/medicinedocs/es/d/Js5513s/2.6.html
Palomino, J. & Pachón, J. (2004). Aminoglucósidos-aminociclitoles: Características estructurales
y nuevos aspectos sobre su resistencia [archivo PDF]. Servicio de Enfermedades Infecciosas.
Hospital Universitario Virgen del Rocío. Recuperado de:
https://scielo.conicyt.cl/pdf/rci/v21n4/art07.pdf
Margulis, L. & Chapman, M. (2009). Kingdoms & domains: an illustrated guide to the phyla of life
on Earth. Boston, USA: Academic Press/Elsevier.
Hasani. A., Kariminik. A. & Issazadeh. K. (2014). Streptomycetes: Characteristics and Their
Antimicrobial Activities. International journal of Advanced Biological and Biomedical Research,
2(1), 63-75. Recuperado de:
http://www.ijabbr.com/article_7033_7733c8235876d7ba635f6c831a916648.pdf
The Editors of Encyclopaedia Britannica (1998). Streptomyces. Encyclopaedia Britannica.
Recuperado de: https://www.britannica.com/science/Streptomyces](https://image.slidesharecdn.com/streptomycesgriseus-200529202038/85/Streptomyces-griseus-9-320.jpg)


